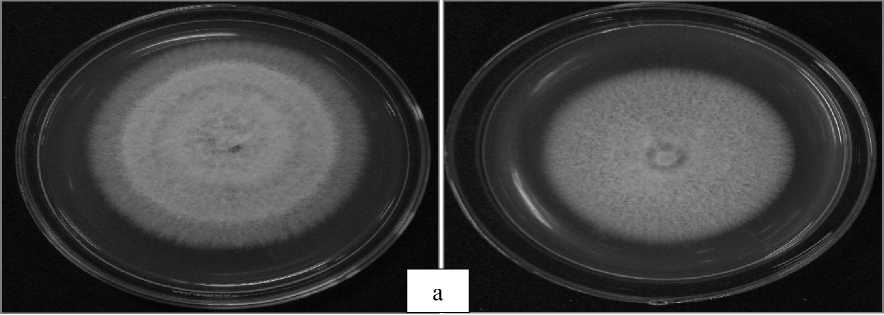

THE EXISTENCE OF ENTOMOPATHOGENIC FUNGI ON RICE PLANTS RHIZOSPHERE
on
INTERNATIONAL JOURNAL OF BIOSCIENCES AND BIOTECHNOLOGY • Vol. 5 No. 1 • September 2017 ISSN: 2303-3371
https://doi.org/10.24843/IJBB.2017.v05.i01.p02
THE EXISTENCE OF ENTOMOPATHOGENIC FUNGI ON RICE PLANTS RHIZOSPHERE
Noerfitryani* and Hamzah
Muhammadiyah Universiy Makassar, Jl. Sultan Alauddin No. 259, Indonesia, 90221
*Corresponding author: yhani.noerfitryani@gmail.com
ABSTRACT
Enthomophatogenic fungi are one of bioinsecticides that can be used as pests control. This research aimed to identify and analyze the existence of fungi on semi-organic and inorganic rice plants rhizosphere and prove the role as entomophatogenic fungi. The research method isolation of fungi was conducted in Takalar Regency, semi-organic and inorganic rice plants rhizosphere and continued in Biological Laboratory, Plant Pests and Diseases Department, Faculty of Agriculture, Universitas Hasanuddin, Makassar. This research using a modified insect bait method, larvae mortality calculated, insect testing were infected in reisolation and fungal diversity index. The result showed that the average Tenebrio molitor larvae mortality infected of enthomopathogenic fungi on semi-organic rhizosphere was around 24% and 8% on inorganic rhizosphere. The percentage of larvae mortality on semi-organic rhizosphere were infected by Fusarium sp., range the percentage was around 20-60 %, Aspergillus sp. 60%-80% and Trichoderma sp. 80%, while in inorganic rhizosphere up to 100% were infected by Aspergillus spp.
Keywords: Semi-organic and inorganic, Rhizosphere, Entomopathogenic
INTRODUCTION
All microorganisms are present in rhizosphere, affect the growth of the plant, nutrient supply for plants, as biological control for pests. Enthomophatogenic fungi as biological agens are commonly found on rhizosphere. But the existence of microorganisms in the soil especially for this time has decreased. This is due to environmental pollution caused by agricultural activity continues that rely on chemical fertilizers (inorganic) and synthetic pesticides. Nutrients secretion into the rhizosphere of plants were influenced by environmental factors and further affect the
abundance and diversity of microorganisms in the area (Kuswinanti et al, 2014).
There are about 700 types of entomopathogenic fungi, which is of 90 genera are represented (Goettel et al., 2010). Several types include Metharizium anisopliae (Priwiratama and Susanto, 2014), Beauveria bassiana (Malekan et al., 2015; Herlinda, 2010), Aspergillus (Bawin et al., 2016) Fusarium, Penicillium, Rhizopus, Trichoderma (Assaf et al., 2011).
Several studies of soil fungi were isolated from rhizosphere and potentially as biological control Trizelia et al., (2011) showed that, isolates Metarhizium spp. which
is isolated from cabbage rhizosphere, virulent to eggs and larvae of Spodoptera litura instar I of larvae, and also Trizelia et al., (2015) showed that there were 3 genera of entomopathogenic fungi in various vegetable crops rhizosphere, Metharizium, Beauveria and Aspergillus with the highest diversity of entomopathogenic fungi were found in the tomato plant rhizosphere. Nurariaty et al., (2013) showed that mortality pupae and imago of cocoa pod borer infected enthomophatogenic fungi genera of Penicillium sp., Aspergillus sp. and Fusarium sp. Refer to Hamdani et al., (2011) there are 6 genus of entomopathogenic fungi were isolated from cocoa rhizosphere in different agroecosystems were Aspergillus, Metarhizium, Beauveria, Paecilomyces, Fusarium and Penicillium effective as controlling C.cramerella insects. However, no previous study has investigated the existence diversity of entomopathogenic fungi in semi organic and inorganic rice rhizosphere in South Sulawesi, therefore this study was conducted for determining control strategy in Integrated Pest Management (IPM) system.
MATERIALS AND METHODS
Soil samples
The present studies were conducted at Plant Pests and Diseases Department, Faculty of Agriculture, Universitas Hasanuddin, Makassar, during April- July. Soil samples
were collected from semi-organic and inorganic rice ecosystem belonging to farmers in North Polongbangkeng SubDistrict Takalar Regency. Determined diagonally 5 points on the semi-organic and inorganic rice plants rhizosphere. Each point was taken in the rhizhosphere, at a depth 2030 cm of soil with a volume of approximately 300 g.
Insect Bait Method
The fungi were isolated by insect bait method (Zimmerman, 1986) modified. Larvae Tenebrio molitor as a test insect, each of 5 larvae were inserted into plastic cups (measuring 10 cm x 16 cm) containing 100 g of filter soil with a sieve 1100 mesh. Then covered with white cloth size 3 cm x 3 cm and were incubated at 22-25 °C. Larvae that were infected of fungi then placed in sterile filter paper were moistened. Larvae were infected of entomopathogenic fungi characterized by the appearance of mycelium of the fungus in each of the insect segment body. Surfaces sterilized using 70% alcohol for 1 minute and then rinsed with sterile distilled water, again kept in sterile distilled water and dry it on sterile filter paper, and then isolated larvae in fresh sterilized petri dish containing PDA and incubated for 3-7 days at 22-25 °C . Thereafter, identified the fungi that grew on PDA.
Bioassay Test of Entomopathogenic Fungi
The fungi that were identified then tested to determine their role as entomopathogen. The fungus was used in this experiment all the fungus obtained. The preparation suspension of spores for each fungus was obtained by the addition 10 ml of
sterile water into the petri dish containing the culture of the fungus for 8 days , then was homogenized by using spatula for 1 minute. Drop suspension on Haemocytometer then the number of spores counted by the formula
t x d
S = ------------------ x IO6
n x 0,25
S = number of spores
T = total number of spores observed in square cell sample
D = dilution factor
N = number of square cell sample observed 0.25 = correction factor
application of suspense in a petri dish (diameter 20 cm), placed 5 larvae of T.
molitor as treatment. Next sprayed as much as 0.1 ml of the suspension of the fungal spores were selected on test insect.
Thereafter 24 hours carried out
Larvae infected by fungi
P = --------------------------------------- x 100%
number of larvae observed
observations of percentage mortality of each larvae. Morphological changes to insect stadia observed discoloration, texture, activity larvae. The percentage mortality of T. molitor larvae was calculated by the formula:
RESULTS AND DISCUSSION
Identification of Enthomophatogenic Fungi
Identification of the fungi isolates were found based on macroscopic and microscopic morphology characteristics. The
result showed that 6 fungi isolates from semi-organic rhizosphere and 2 isolates from inorganic rhizosphere have various characteristic. Microscopic and macroscopic characteristics for each fungus on (Table 1 and Table 2.)
Table 1. Cultural Characteristics of Various Isolates Fungi on PDA Isolated from Semi-organic Rhizosphere
|
Upper Surface |
Colon |
Hyphae | ||||||
|
Isolate s |
Color and Cultural aspect |
Densit y |
Zonation |
y Revers e |
Conidia / Spores |
Color |
Setae / None |
Genera |
|
RSOT 1 |
Light greenish, powdery, white halo (margin) and cotton-like |
High |
Concentr ic zones |
Cream |
Globose |
Hyalin e |
Setae |
Aspergillus |
|
RSOT 2 |
Light green, powdery, white halo |
High |
Concentr ic zones |
Cream |
Globose |
Hyalin e |
Setae |
Apergillus |
|
RSOT |
White, cottonlike |
High |
None |
White |
Macroconid ia slightly curve, microconidi a bent |
Hyalin e |
Setae |
Fusarium |
|
3 |
White to dark green, light green halo, cotton-like |
High |
Concentr ic zones |
White |
Ovoid |
Hyalin e |
Setae |
Trichoderm a |
|
RSOT |
White to creamish, creamish halo, cotton-like |
High |
Concentr ic zones |
Yello w |
Macroconid ia slightly curve, microconidi a ovoid |
Hyalin e |
Setae |
Fusarium |
|
4 |
White to creamish, creamish halo, cotton-like |
High |
Concentr ic zones |
Yello w |
Macroconid ia slightly curve, microconidi a ovoid |
Hyalin e |
Setae |
Fusarium |
Note: Identification based on determination keys of the identification books (Barnett and Hunter, 1972; Watanabe, 2002).
Table 2. Cultural Characteristics of Various Isolates Fungi on PDA Isolated from Inorganic Rhizosphere
|
Isolates |
Upper Surface |
Colony Reverse |
Conidia / spores |
Hyphae |
Genus | |||
|
Color and |
Zonation | |||||||
|
Color |
Setae/ None | |||||||
|
Texture |
Density | |||||||
|
Black spores, |
Single |
Hyalin e | ||||||
|
powdery, |
High |
concentric |
White |
Globose |
Setae |
Aspergillus | ||
|
RIOT1 |
white halo |
zone | ||||||
|
Light green, powdery, white halo |
High |
Concentri c zones |
Cream |
Globose |
Hyalin e |
Setae |
Aspergillus | |
Note: Identification based on determination keys of the identification books (Barnett and Hunter, 1972; Watanabe, 2002).
Table 1 showed that 3 genera morphological identification were Fusarium, Trichoderma and Aspergillus, while on Table 2 showed that one genera, thas was
Aspergillus. The macroscopic and microscopic characteristics of the three types of fungi on (Figures 1-4).

Fig. 1. Macroscopic (a) and microscopic of Aspergillus, conidiophore (b), hypha with setae (c), conidia (d)

Fig. 2. Macroscopic (a) and microscopic of Trichoderma, hypha with setae (b), conidia and conidiophores (c)

Fig. 3. Macroscopic (a) and microscopic of Fusarium, hypha with setae (b), microconidia and macroconidia (c), chlamydospores (d)

Fig. 4. Macroscopic (a) and microscopic of Aspergillus, conidiophores (b), conidia and hypha with setae (c).
Bioassay Test of Enthomophatogenic Fungi
Six isolates were isolated from semi-organic rhizosphere, there were three isolates of Fusarium sp, two isolates of
Aspergillus sp., one isolate of Trichoderma sp. Each of the fungi was found in application on test insects, the average mortality of test insects on (Table 3).
Table 3. Mortality of T. molior Larvae Infected of Fungi on Semi-organic Rhizosphere
|
Isolates |
Genera |
% Mortality of Larvae |
|
RSOT1 |
Aspergillus |
80 |
|
RSOT2 |
Aspergillus |
60 |
|
RSOT3 (1) |
Fusarium |
20 |
|
RSOT3 (2) |
Trichoderma* |
80 |
|
RSOT4 (1) |
Fusarium |
60 |
|
RSOT4 (2) |
Fusarium |
60 |
Note: *) Test insects of dead larvae, but the mycelia did not exit through the insect host and the numbers in brackets on the isolates showed that the larvae to-
Table 3 showed that the percentage of larvae mortality were infected of enthomophatogenic fungi on semi-organic rhizosphere, the percentage mortality infected by genera of Aspergillus sp. range the percentage was around 60-80 % isolates of RSOT1 and RSOT2, Fusarium sp. 20%-
60% isolates of RSOT3 (1), RSOT4 (1) and RSOT4 (2), Trichoderma sp. 80% isolate of RSOT3 (2).
Two isolates isolated from inorganic rhizosphere were Aspergillus spp., the average mortality of test insects on (Table 4).
Table 4. Mortality of T. molitor Larvae Infected of Fungi on Inorganic Rhizosphere
|
Isolates |
Genera |
% Mortality of Larvae |
|
RIOT1 (1) |
Aspergillus |
100 |
|
RIOT1 (2) |
Aspergillus |
60 |
Table 4 showed that the percentage of larvae mortality were infected of enthomophatogenic fungi on inorganic rhizosphere, the percentage mortality infected by genera of Aspergillus spp. were
isolate of RIOT1 (1) 100%, while isolate of RIOT1 (2) percentage of larvae mortality around 60 %. Entomopathogenic fungi that were infected and application T.molitor larvae on (Figure 5).

Fig. 5. Larvae T.molitor were infected of Fusarium sp. (a) and Aspergillus flavus (b) Aspergillus niger (RIOT1 isolate) (c)
The growth of fungi in culture media for 7 days isolated from semi-organic rhizosphere showed that as long as incubation period increase the growth of fungi colony diameter. This was occured in all type of fungi, which were isolates of
RSOT3(2) genera of Trichoderma sp. has rapid growth on PDA, followed by isolates of RSOT4 (1), RSOT4 (2), RSOT2, RSOT3 (1) and RSOT1 on (Figure 6) and from inorganic rhizosphere were isolates RIOT1 (1) and RIOT1 (2) on (Figure 7).

Growth ofFungi in Culture Media
≡ io
—•— Isolate
6
-∙- Isolate
^♦— Isolate
0
—•— Isolate
Incubation Period (days)
^♦— Isolate
Fig. 6. The average growth of fungi in PDA media for 7 days on semi-organic rhizosphere

Fig. 7. The average growth of fungi in PDA media for 7 days on inorganic rhizosphere
Percentage of larvae mortality infected by enthomophatogenic fungi were different between semi-organic rhizosphere and inorganic rhizosphere. Semi-organic rhizosphere were found 6 isolates from 3 genera of enthomophatogenic fungi while in inorganic rhizosphere were found 2 isolates from one genera. It caused of the conidial density of each entomopathogenic fungus on semi-organic rhizosphere as well as favorable environmental conditions. It was knew that on semi-organic rhizosphere were treated with organic materials were used fertilizer, biological pesticides, prioritize using organic materials that organic materials were an important ingredient for soil fertility,
physically, chemically and in terms of soil biology. Refer to Doeswono (1983), the organic materials were a source of energy and food for microorganisms living in the soil. Soil microorganisms interact with organic material because their provide carbon as a source of energy to grow. The high percentage of larvae mortality infected on semi-organic rice plants rhizosphere because total of conidia and spores present in the rhizosphere. Tanada and Kaya (1993) showed that the density of pathogens or inoculum is one important factor of infection in insects. Soil microorganisms have an important role in biogeochemical processes that determine the productivity of the plant as
a microbial inoculant and affect on soil health. The dominant genera in all the agricultural crop fields were Aspergillus, Penicillium and Mucor species (Chandrashekar et al., 2014).
On semi-organic and inorganic rhizosphere were found genera of Aspergillus spp. (Tables 1 and 2.), refer to Hidayat (2010) showed that enthomopathogenic fungi were isolated from agricultural fields genera of Aspergillus the most commonly were found. A. flavus subsists as mycelium, conidia, or sclerotia is one of the soil components associated with the soil organic materials (Hedayati, et al. 2007). Aspergillus spp. are able to assimilate minerals from minimal medium and survive on simple carbon and nitrogen sources with no vitamin requirements (Tarrand et al. 2005).
Previous studies have reported 11 isolates of fungi were found in two different locations on the chasew plants rhizosphere were Aspergillus flavus, A. niger, A. parasiticus, Botrytis cinera, Cladosporium
sphacospermum, Fusarium sporotrichioides, Penicillium brevicompactum, P. citrinum, P. chrysogenum, Rhizopus stolonifer and Synchephalastrum racemosum (Wulandari et al., 2011). Genera of fungi were isolated on the rhizosphere soil and rizoplan cassava plants cultivar TME 419 were Alternari, Aspergillus, Acremonium, Brettanomyces, Botrytis, Byssochlamys, Cladosporium, Doratomyces, Geotrichum, Humicola, Moniliella, Monascus, Neurospora, Oidiodendron, Penicillium, Pyricularia, Papulaspora, Rhodotorula, Rhizopus, Saccharomyces, Sporothrix, Trichothecium and Trichoderma (Sule and Oyeyiola, 2012).
The larvae mortality by discoloration of the insect cuticle from light brown to dark brown and some subsequently were transformed into black color, characterized of conidia enthomophatogenic fungi penetrating the cuticle entry of insect host and absorbing insect host fluids. Then the mycelium exit through on host surface (e.g. the caput and abdomen) covered all of host surface and growth on the host surface. Refer to Humber
(2008) showed that the life cycle of entomopathogenic fungi against the insect cuticle with spore germination and penetration, thereafter proliferation of cells in the fungus that eventually are causing the death of its host, death of the insects followed by the production of infective spores entry the host immediately to repeat it life cycle. The pathogenicity of fungal species was thought related to produce enzymes and mycotoxins during infection of the insect on contact with the cuticle and in hemosoel (Tanada and Kaya, 1993).
PDA has significant effect on the growth of fungal colony diameter, the growth of eight isolates on PDA are presented on (Figs. 6 and 7), PDA is a good medium for the culture of Fusarium, Aspergillus and Trichoderma, the growth of all isolates remained significantly high on this medium. PDA is one of the most commonly used culture media because of its simple formulation and its ability to support mycelial growth of a wide range of fungi (Sharma and Pandey, 2010).
CONCLUSIONS
Semi-organic rice plants rhizosphere were found six isolates genera of Fusarium sp., Trichoderma sp. and Aspergillus sp., while and on inorganic rice plants were found 2 isolates genera of Aspergillus spp. have a role as enthomophatogenic fungi.
ACKNOWLEDGEMENT
Authors would like to thank Ministry
of Research, Technology and Higher Education for providing the financial.
REFERENCES
Assaf, L. H., Haleem, R. A., & Abdullah, S.
K. (2011). Association of
Enthomophatogenic and Other
Opportunistic Fungi with Insects in Dormant Locations. Jordan Journal of Biological Science, 4. 87-92.
Barnett, H. L., & Hunter, B. B. (1972). Illustrated Genera of Imperfect Fungi. Mineapolis. United States of America: Burgess Publishing Company.
Bawin, T., Seye, F., Boukraa, S., Jean-Yves, Z., Fara, N .R., Quentin, Z., Mady N., Farnk D,. & Frédéric F. (2016).
Production of Two Enthomophatogenic Aspergillus species and insecticidal activity against the Mosquito Culex quinquefasciatus compared to
Metharizium anisoplae. Journal of Biocontrol Science and Technology, 26: 617-629.
Chandrashekar, M. A., Pai, K. S., & Raju, N. S. (2014). Fungal Diversity of
Rhizosphere Soils in Different Agricultural fields of Nanjangud Taluk of Mysore Karnataka India. International Journal of Current Microbiology and Applied Science, 3 (5) : 559-566.
Goettel, M. S., Eilenberg, J,. & Glare, T. R. (2010). Entomopathogenic Fungi and their Role in Regulation of Insect Populations. In Gilbert, L.I. & Gill, S.S. (Eds.), Insect Control Biological and Synthetic Agents.( p.p. 387- 431).
Hamdani., Yaherwandi., & Trizelia. (2011).
Potensial of Indigenous
Enthomophatogenic Fungi as
Biological Control of Cocoa Pod Borer, Conopomorpha cramerella Snell (Lepidoptera: Gracillariidae).
Journal of Manggaro. 12 (2): 75-80.
Hedayati, M.T., Pasqualotto, A.C., Warn, P.A., Bowyer, P., & Denning, D.W. (2007). Aspergillus flavus: human pathogen, allergen and micotoxin producer. Journal of Microbiology. 153: 1677-1692.
Herlinda, S. (2010). Spore Density and Viability of Enthomopathogenic Fungal Isolates from Indonesia and their Virulence against Aphis gossypii Glover (Homoptera: Aphididae). J. of Tropical Life Sci. Res. 21 (1):13-21.
Hidayat, Y. (2010). Isolation of Enthomopathogenic Fungi on infected insects on Agricultural Fields X Koto Tanah Datar Regency. J.of Saintek. 2(2) : 99-104.
Humber, R. A. (2008). Evolution of Entomopathogenicity in Fungi. J. of Invertebrate Pathology. 98: 262-266.
Kuswinanti, T., Baharuddin, & Sukmawati S. (2014). Effectiveness of Bacterial Isolates from Several Rhizospheres and Organic Materials against Ralstonia solanacearum and Fusarium
oxysporum on Potato. Journal of Phytopathology Indonesia. 10 (2): 6872.
Malekan, N., Hatami, B., Ebadi, R., Alireza, A., & Rouhollah R. (2015). Evaluation of Enthomophatogenic fungi Beauveria
bassiana and Lecanicillium muscarium on different nymphal stages of greenhouse whitefly Trialeurodes vaporariorum in greenhouse
conditions. Journal of Biharean Biologist, 9 (2): 108-112.
Nurariaty, A., Saranga, P. A., Rosmana, A., & Tambingsila, M. (2013). Potential of Rhizosphere Fungi as Biological Control Agent of Cocoa Plant Pests and Diseases. Proceedings of National Seminar and Congres of PFI XXI, Padang, 08-10 October 2013.
Priwiratama, H,. & Susanto A. (2014).
Utilization of Fungi for the Biological Control of Insect Pests and Ganoderma Disease in the Indonesia Oil Palm Industry. Journal of Agriculture Science and Technology. 4:103-111.
Sharma, G., &Pandey, R.R. (2010). Influence of Cultural Media on Growth, Colony Character and Sporulation of Fungi isolated from Decaying Vegetables Wastes. J. of Yeast and Fungal Res. 1 (8) 157-164.
Sule, I. O., & Oyeyiola, G.P. (2012). Fungi in the Rhizosphere and Rhizoplane of Cassava cultivar TME 419.
International Journal of Applied Biological Research. 4 (1,2) : 18 - 30.
Tanada, Y., & Kaya, H.K. (1993). Insect Pathology. New York: Academic
Press, Inc.
Tarrand, J. J., Han, X. Y., Kontoyiannis D. P., & May G. S. (2005). Aspergillus hyphae in infected tissue: evidence of physiologic adaptation and effect on culture recovery. Journal of Clinical Microbiology 43 (1) 382–386.
Trizelia, Syahrawati M., & Mardiah A.
(2011). Pathogenicity Some Isolates of Enthomopathogenic fungi Metarhizium spp. against egg of Spodoptera litura Fabricius (Lepidoptera: Noctuidae). J. of Enthomology Indonesia. 8: (1) 4554.
Trizelia, Armon N., & Jailani H. (2015). The Diversity of Entomopathogenic Fungi on Rhizosphere of Various Vegetable Crops. Proceedings of National
Seminar of Biodiversity Society
Indonesia, August 2015. pp. 998-1004. Watanabe, T.(2002). Pictorial Atlas of Soil and Seed Fungi. Morphologies of Cultured Fungi and Key to Species. (2nd Ed). CRC Press LCC. New York, Wahington, D.C.
Wulandari, N. L. D., Proborini, M. W., & Sundra I.K. (2013). Eksploration of Soil Fungi Spatial on Cashew Plants Rhizosphere (Anacardium
Occidentale L.) at Karangasem and Buleleng-Bali. Simbiosis J. of Biological Sci. 1 (2): 85-101.
Zimmermann, G. (1986).The Galleria Bait Method for Detection of
Entomopathogenic Fungi in Soil.
Journal of Applied Entomology.
102:213-215.
24 • ASIA OCEANIA BIOSCIENCE AND BIOTECHNOLOGY
Discussion and feedback